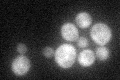
YKL191W
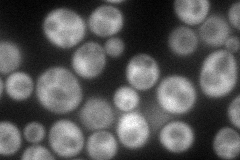
YKL191W
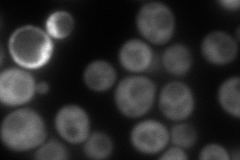
YKL191W
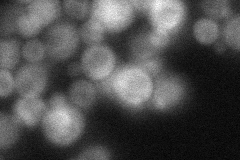
YKL191W
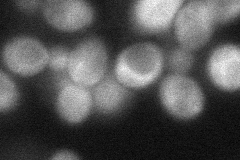
YKL191W
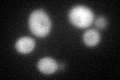
YKL191W
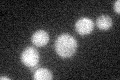
YKL191W

View description
Protein required, along with Dph1p, Kti11p, Jjj3p, and Dph5p, for synthesis of diphthamide, which is a modified histidine residue of translation elongation factor 2 (Eft1p or Eft2p); may act in a complex with Dph1p and Kti11p
Localization:
Intensity:
Fold change:
Significance:
-
C’ GFP library in SD
cytosol42.5 -
N' NOP1pr-GFP in SD
cytosol100.609 -
N' TEF2pr-mCherry in SD
cytosol140.602 -
N' NATIVEpr-GFP in SD
cytosol42.6663 -
N' TEF2pr-VC and Cyto-VN in SD
cytosol55.7782 -
C’ GFP library in SD+DTT
cytosol36.810.86No -
C’ GFP library in SD+H2O2

cytosol43.621.02No -
C’ GFP library in Starvation Media
cytosol25.190.59No -
C’ GFP library on the background of Pup2-DaMP

cytosol -
C’ GFP library on the background of CCT mutant

cytosol46.84511.10204No
